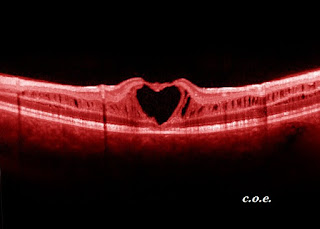

Los
médicos estamos habituados a que se nos consulte prácticamente en cualquier
parte. En cuanto los vecinos conocen que somos médicos, la pregunta en el
rellano o en el parque por la cefalea del vecino del quinto salta en la primera
ocasión. Si acudimos a una cena, después de una semana estresante con guardias
y dolencias que nos salen por las orejas, se sienta enfrente el amigo del amigo
de un amigo, quien, en los postres, cuando empieza a tomarse confianza,
comienza a describirnos el aspecto de sus esputos, la frecuencia de sus
flatulencias y el olor de su aliento. Acaba la cena y, de vuelta a casa, las
cosas cambian. Y es que “en casa de herrero, cuchara de palo”.
En casa
pueden acontecer dos escenarios. El primero es que nuestra familia nos ignore.
Resulta que estamos estudiando todo el día, viendo pacientes sin parar y hemos
pasado años de trabajo para llegar donde estamos, y nuestra madre no se fía de
nosotros cuando le decimos que se tome un paracetamol para el resfriado. “Iré al
Doctor Ramírez, que él me conoce y sabe mejor lo que tengo que tomar”. Vamos,
que nuestra madre nos dice, básicamente: hijo mío, eres estupendo, pero como
médico no vales un pimiento. Ante estas actitudes de ignorancia doméstica hacia
nuestra sapiencia hay médicos que piensan: “ufff, mucho mejor, me quito de
encima la responsabilidad de ser el médico de mi madre”. Sin embargo, a otros
les salta el orgullo herido: “pero mamá, ¿cómo que al Doctor Ramírez? ¿es que
te piensas que no se tratar un resfriado?”.
El otro
escenario que nos podemos encontrar en casa es el contrario. Llegamos a las
doce de la noche de la cena y vemos que tenemos varios WhatsApp de una prima
porque ha estado en urgencias por una infección de orina y nos pregunta qué
pensamos del tratamiento que le han puesto. A las 9:00h de la mañana ya está
sonando el teléfono y ahora es nuestra madre (en la versión “mi hijo lo sabe
todo”) poniéndonos al día sobre sus dolores articulares y sobre los cambios que
le ha hecho el Doctor Ramírez en su tratamiento esta semana (en esta versión,
somos más listos que el Doctor Ramírez). A partir de ahí, tenemos un largo fin
de semana de guardia con la familia, con sus amigos y allegados, y con el grupo
de japoneses que nuestra hermana se ha encontrado en el Metro con
gastroenteritis.
¿Con qué
versión nos quedamos? La primera es la que realmente se corresponde con ese
herrero que cuando llega a casa come con cuchara de palo porque su ciencia no
vale de puertas para adentro. La segunda sería más bien algo así como “en casa
de herrero cuchara de hierro, los vasos de acero y los platos de chapa”. Porque
chapa, desde luego un rato.
Posiblemente
ninguno elegimos realmente si comemos con cuchillo de palo o de hierro. O tal
vez sí un poco. Porque es cierto que no hemos escogido a la madre que tenemos,
ni a los primos ni a los primos de los primos. Pero sí que elegimos la actitud
que tomamos cuando nos preguntan. Podemos ser condescendientes y explicar todo,
llamar preguntando cómo está nuestra madre del resfriado o cómo se encuentran
los japoneses de la gastroenteritis, y hasta telefonear al Doctor Ramírez para
saber por qué le ha mandado metamizol a nuestra madre, y después decirle que se
tome paracetamol, porque nosotros somos “los que sabemos”. Otra actitud consiste
en ponernos bordes. “Mamá, ¿ya estás de nuevo con tus chorradas? Anda, que te
aguante el Doctor Ramírez, que pobrecillo”, “mira querida, los japoneses que se
hubieran quedado en Tokio, pero si vienen a España que espabilen con el ali
oli”.
Detrás de
estos perfiles exagerados de familias (insistentes y desconfiadas) y de médicos
(preocupados y desentendidos), estamos todos nosotros. Posiblemente no
cuadremos con ninguno de ellos al completo y haya un poquito de aquí y otro de
allí, tanto en nosotros como en nuestra familia. Pero lo que es incuestionable
es que nuestra tarea como médicos no finaliza cuando salimos del hospital o del
centro de salud. Y no nos referimos sólo a la obligación que tenemos de
pararnos ante un accidente. Cuando entramos en casa y en las reuniones
familiares, seguimos siendo médicos.
El
filósofo argentino afincado en Norteamérica Mario Bunge, publicó en 2012 el
extraordinario libro “Filosofía para médicos”. Entre otras muchas cosas, Bunge
expone cómo los médicos tenemos una moral espacial: “los médicos responsables
aspiran a dispensar la mejor atención posible al mayor número”, lo que incluye
a nuestros familiares. Para Bunge el médico tiene que estar siempre dispuesto a
acudir a la llamada. Visto así, se trata de la vocación más dura, porque otras
personas también disponibles en todo momento no tienen que atender problemas de
salud, lo más serio e importante para casi todos. Si conocemos la biografía de
Mario Bunge, de padre médico y madre enfermera, podremos entender su
sensibilidad hacia nuestra profesión.
Si no
podemos escoger a nuestra familia, sea (generalizando) del tipo “insistente” o
del “desconfiado”, sí que podemos decidir respecto a nuestra actitud:
¿preocupados o desentendidos? Cada uno debe escoger, pero es bueno
considerar varios aspectos antes de elegir.
Por una
parte, todos tenemos derecho, y casi la obligación, de desconectar del trabajo,
algo que tienen que entender las personas que nos aprecian. Otro aspecto es que
hay que saber marcar límites: cuándo tenemos que dar nuestra opinión y actuar y
cuándo es mejor dejarla a un lado (por ejemplo, cuando ese desconocido nos
describe sus esputos en los postres). Por último, y trayendo de nuevo a Mario
Bunge, tal y como señala en la parte final del libro, los médicos “cumplen así,
sin saberlo, la máxima humanista Disfruta de la vida y Ayuda a vivir”. Es
decir, que en nuestra casa, lugar de distensión y de disfrute, también podemos
ayudar a vivir gracias a nuestra ciencia y experiencia.
OFTALMÓLOGO
ESTEPONA